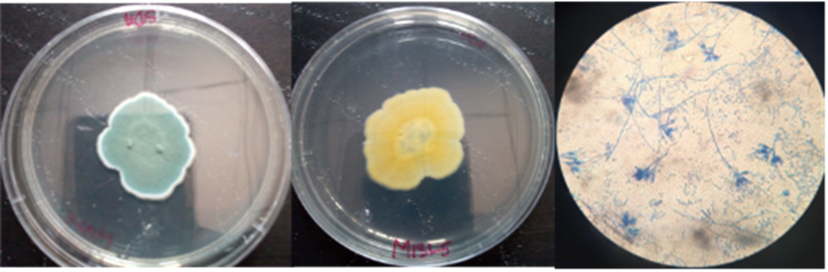

The Microbiome and Anti-Microbial Resistance Unit of REFOTDE is a laboratory devoted to the culturing, examination, and identification of microorganisms including bacteria, fungi (moulds and yeasts), and some viruses etc. Our role which include the isolation and characterisation of microorganisms causing infections in humans, animal and environment has two important functions among others; regular basis disease management at clinical level and deep knowledge on the presence, source, and transmission mode of an infective microbe in the environment, animal and human (One Health) at the epidemiological level.
The Microbiome and Anti-Microbial Resistance Unit of REFOTDE is supervised by Professor Samuel Wanji and a panel of professionals with proper educational qualifications and training. The unit accept, assist and train students within and out of the University of Buea.

At the Microbiome and Anti-Microbial Resistance Unit of REFOTDE, GMP which comprises of aseptic techniques and other good microbiological techniques/practices are of utmost importance in preventing contamination of the laboratory when handling microorganisms. GMP employs microbiological laboratory techniques or microbiology laboratory procedures to keep the microorganisms in their safe place without coming in contact with other organisms and the people around. Thus, extracting the research result without any adulteration or contamination is our ultimate goal.
Some of Our Recent Publications
1. Phenotypical characterization, and antibiotics susceptibility patterns of skin bacteria found in podoconiosis patients in the North West Region of Cameroon. BMC Microbiology (2023) 23:189 https://doi.org/10.1186/s12866-023-02923-9
Derick Lekealem Nkwetta1,2,3, Bangsi Rose Fuen1,2,3, Njodzeka Flora Yenban1,2,3, Nancielle Mbiatong1,2,3, Gordon Takop Nchanji1,2,3, John Bonekeh3, Bertrand Lontum Ndzeshang1,2,3, Narcisse Victor Tchamatchoua Gandjui1,2, Fanny Fri. Fombad1,2,3, Ute Klarmann-Schulz4,5, Mathias Eyong Esum1,2, Abdel Jelil Njouendou2,3,6, Jerome Fru Cho1,2,3, Achim Hoerauf4,7, Manuel Ritter4† and Samuel Wanji1,2,3*†
2. Tropical leg lymphedema caused by podoconiosis is associated with increased colonisation by anaerobic bacteria. Scientific Reports (2023) 13:13785 https://doi.org/10.1038/s41598-023-40765-7
Claudio Neidhöfer1, Derick Lekealem Nkwetta2,3, Bangsi Rose Fuen2,3, Njodzeka Flora Yenban2,3, Nancielle Mbiatong2,3, Gordon Takop Nchanji2,3, Patricia Korir1, Nina Wetzig4, Martin Sieber4, Ralf Thiele4, Marijo Parcina1, Ute Klarmann‑Schulz1,5, Achim Hoerauf1,5,6, Samuel Wanji2,3,7 & Manuel Ritter1,7*

